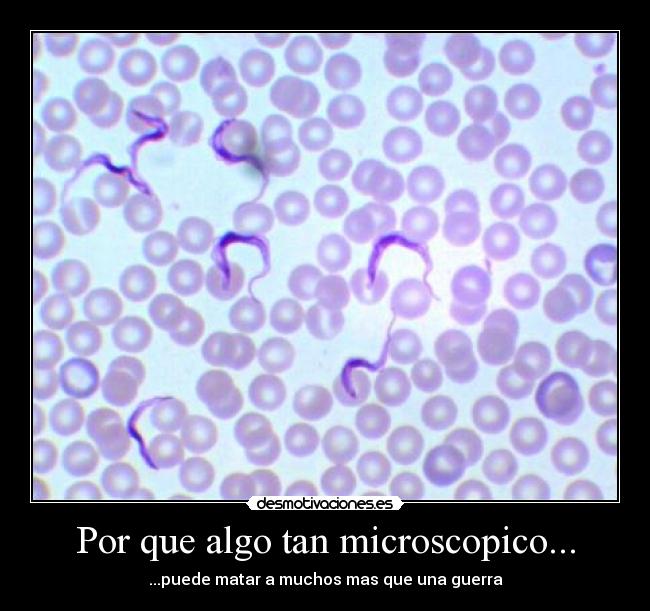
carteles tripanosoma desmotivaciones

Por que algo tan microscopico...
La colaAñadido por yoyocas | Comentar(2)
Imágenes, Carteles y Desmotivaciones de tripanosoma
LOS MEJORES CARTELES DE
abrazos alegria alma amigos amistad amor animales anime arte ausencia ayuda besos bogota caracter casa celos cine comida confianza corazon chiste criticas debilidad deportes desamor deseos desmotivaciones destino dinero dios distancia dolor dormir enemigo enfados escuela espana esperanza examenes facebook fail familia felicidad fiesta filosofia fisico frases futbol gatos graciosas guerra hipster historia humor ideas idioma ignorancia imaginacion imposible infancia internet libertad literatura llorar locura madre madurar memes mentira mexico miedo motivaciones muerte mujer mundo musica naruto naturaleza navidad obstaculos odio olvidar padre padres pasado pensamientos pokemon politica problemas promesas recuerdos religion risa rock sentimientos sexo silencio simpsons sociedad soledad sonrisa sueños tatuajes tetas tonto trabajo tristeza tuenti verano vida videojuegos
Número de visitas: 12114853761 | Usuarios registrados: 2075977 | Clasificación de usuarios
Carteles en la página: 8020879, hoy: 9, ayer: 20
blog.desmotivaciones.es
Contacto | Reglas
▲▲▲
Carteles en la página: 8020879, hoy: 9, ayer: 20
blog.desmotivaciones.es
Contacto | Reglas
▲▲▲


Comentarios (2)
beatriz_k95Iniciar sesión, para comentar tienes que registrarte.